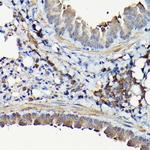
YAP1 Antibody in Immunohistochemistry (Paraffin) (IHC (P))

Search
Invitrogen
YAP1 Polyclonal Antibody
{{$productOrderCtrl.translations['antibody.pdp.commerceCard.promotion.promotions']}}
{{$productOrderCtrl.translations['antibody.pdp.commerceCard.promotion.viewpromo']}}
{{$productOrderCtrl.translations['antibody.pdp.commerceCard.promotion.promocode']}}: {{promo.promoCode}} {{promo.promoTitle}} {{promo.promoDescription}}. {{$productOrderCtrl.translations['antibody.pdp.commerceCard.promotion.learnmore']}}

Please note: We are reviewing Western blot images included in the antibody testing data in our catalog, including those provided by third parties. Unless expressly labeled or annotated as “raw-unedited”, Western blot images included in the antibody testing data in our catalog may have been edited, optimized or otherwise adjusted for presentation.
产品信息
PA5-120528
种属反应
宿主/亚型
分类
类型
抗原
偶联物
形式
浓度
规格
纯化类型
保存液
内含物
保存条件
运输条件
RRID
产品详细信息
Positive test controls include: A-549, DU145, NIH/3T3, HeLa, Mouse lung. The target is usually found in the following locations: Cytoplasm, Nucleus.
Immunogen sequence: QGGVLGGGSS NQQQQIQLQQ LQMEKERLRL KQQELFRQAI RNINPSTANA PKCQELALRS QLPTLEQDGG TPNAVSSPGM SQELRTMTTN SSDPFLNSGT YHSRDESTDS GLSMSSYSIP RTPDDFLNSV DEMDTGDTIS QSTLPSQQSR FPDYLEALPG TNVDLGTLEG DAMNIEGEEL MPSLQEALSS EILDVESVLA ATKLDKESFL TWL
靶标信息
YAP (Yes-Associated Protein) is a founding member of the WW domain family of proteins, transcriptional co-activator and oncogene. Its gene is transcriptionally activated in squamous cell carcinoma cells. YAP can act both as a coactivator and corepressor and is the critical downstream regulatory target in the Hippo signaling pathway. The Hippo signaling pathway plays a pivotal role in organ size control and tumour suppression by restricting proliferation and promoting apoptosis. Also plays key roles in tissue tension, 3D tissue shape, cell proliferation, cell death, and cell migration. Mutations in the IRF5 gene results in coloboma.
⚠WARNING: This product can expose you to chemicals including mercury, which is known to the State of California to cause birth defects or other reproductive harm. For more information go to www.P65Warnings.ca.gov.
仅用于科研。不用于诊断过程。未经明确授权不得转售。
篇参考文献 (0)
生物信息学
蛋白别名: 65 kDa Yes-associated protein; Protein yorkie homolog; Transcriptional coactivator YAP1; Yes-associated protein 1; Yes-associated protein YAP65 homolog; yes-associated protein, 65 kDa; yorkie homolog
基因别名: AI325207; Yap; YAP1; YAP65; Yki; Yorkie
UniProt ID: (Rat) Q2EJA0, (Mouse) P46938
Entrez Gene ID: (Rat) 363014, (Mouse) 22601




